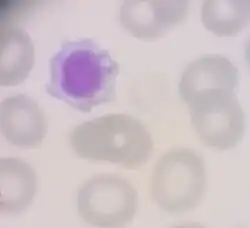

Macrotrombocitopenias hereditarias
Las macrotrombocitopenias hereditarias son un grupo heterogéneo de enfermedades que asocian trombocitopenia y plaquetas gigantes. Pueden incluir todos o algunos de los siguientes rasgos clínicos: nefritis hereditaria, sordera neurosensorial, cataratas e inclusiones leucocitarias. La tendencia hemorrágica suele ser leve y de tipo mucocutáneo en los casos en los que ésta existe (alrededor del 40%), si bien también se ha descrito algún caso de hemorragia postoperatoria grave.[1][2] La mayoría de los pacientes no requieren tratamiento, excepto cuando van a ser sometidos a algún procedimiento invasivo.
Estas enfermedades pueden ser heredadas de forma autosómica dominante, autosómica recesiva o ligada al cromosoma X.
Desórdenes plaquetarios asociados
Los cinco desórdenes plaquetarios, autosómicos dominantes, que asocian macrotrombocitopenia son los síndromes de: May-Hegglin, Epstein, Alport-like, Fechtner y Sebastián.[3]
1. La May-Hegglin fue la primera macrotrombocitopenia descrita, y asocia inclusiones leucocitarias.[4]
2. El Síndrome de Epstein es similar al de Fechtner y al Alport-like, excepto en las cataratas e inclusiones leucocitarias que no han sido descritas.[5]
3. El Síndrome de Fechtner, es un trastorno plaquetario caracterizado por la presencia de macrotrombocitopenia asociada a la presencia de inclusiones granulocitarias, morfológicamente características; y manifestaciones clínicas propias del síndrome de Alport, como nefritis intersticial, sordera y alteraciones oculares (principalmente opacidades del cristalino).[6][7][8] La afectación renal y la sordera no suelen ocurrir hasta la tercera o cuarta década de la vida.[9]
4. El Síndrome de Alport-like es similar al de Fechtner, excepto en que las inclusiones leucocitarias no han sido descritas y se diferencia de la forma clásica, ligada al cromosoma X, del síndrome de Alport en que la mutación genética COL4A5 no está presente.
5. El Síndrome de Sebastián es la última macrotrombocitopenia descrita, en 1990 por Greinacher et al.[10] Se caracteriza por la presencia de macrotrombocitopenia e inclusiones leucocitarias similares a las del síndrome Fechtner; pero sin las manifestaciones clínicas propias del síndrome de Alport (sordera neurosensorial y nefritis).
Etiopatogenia
Hasta hace pocos años, eran macrotrombocitopenias de etiología desconocida. Actualmente, se ha identificado la alteración que las origina, se trata de una mutación alélica del gen 9 (MYH9) para la cadena pesada de la miosina no muscular IIA, NMMHC-IIA,[11][12][13][14][15][16] que se ha identificado en el brazo largo del cromosoma 22 (22q12.3-q13.2).[17][18][19][20] Todos estos datos sugieren que estos desórdenes plaquetarios están causados por mutaciones en el gen MYH9, por lo que se propuso el nombre del “síndrome de MYHAIIA o de MYH9” para agruparlos a todos.[13]
La base biológica que justificaría la tendencia al sangrado en el síndrome de May-Hegglin y en el de Sebastian fue descrita por Dipumpo et al,[21] que demostró una disminución de los niveles de la expresión del complejo GPIb-V-IX en la superficie de las plaquetas de estos pacientes. Esto implicaría una anormal adhesión de la plaqueta al vaso así como de la anormal agregación plaqueta-plaqueta causada por unos niveles descendidos de GPIb-V-IX.
Clínica
Las manifestaciones clínicas hematológicas pueden ser muy variables. La mayoría de los pacientes presentan una historia de tendencia al sangrado de carácter leve pero recurrente o están asintomáticos, aunque también se han descrito pacientes que han presentado hemorragias postquirúrgicas severas.[1][2]
La anemia aguda es casi siempre debida a una hemorragia. La causa y la rapidez de instauración, de la misma, deberán determinar la actuación terapéutica. Se transfundirán concentrados de hematíes, solamente, si existen síntomas de hipoxia tisular.[22]
Diagnóstico
La valoración de la morfología plaquetaria, en el frotis de sangre periférica, es importante para descartar la presencia en el mismo de plaquetas grandes que orienten hacia un posible diagnóstico de síndromes hereditarios de macrotrombocitopenia.
Todos estos síndromes, macrotrombocitopénicos, comparten la tríada de trombocitopenia, plaquetas grandes e inclusiones leucocitarias características. El número de plaquetas puede variar entre 120 000 plaquetas/mm3 en los casos leves y las 20 000 plaquetas/mm3 en los casos severos, con un volumen plaquetario medio de 15-20 fL. El número de megacariocitos y la cinética de las plaquetas son generalmente normales.
Diagnóstico diferencial
El diagnóstico diferencial de las macrotrombocitopenias es muy amplio, debiendo realizarse con aquellas alteraciones que presentan trombocitopenia asociada con plaquetas grandes (elevado volumen plaquetario medio): el síndrome de Bernard-Soulier, el síndrome de Montreal Platelet, el síndrome Gray Platelet y púrpura trombocitopénica autoinmune (PTI). De la misma manera, hay que hacer diagnóstico diferencial con la patología que pueda causar trombocitopenia debida a una trombopoyesis ineficaz: síndrome Wiskott-Aldrich, síndrome de Greaves, déficit de trombopoyetina, y anemia megaloblástica. Finalmente, en el diagnóstico diferencial, incluiremos aquellas situaciones en las que puedan estar presentes las inclusiones leucocitarias, cuerpos de Döhle: septicemia, alteraciones mieoloproliferativas, y embarazo. La PTI es la causa más común de trombocitopenia en la infancia, y también se asocia con la presencia de plaquetas grandes.[23] El diagnóstico diferencial con la PTI puede ser difícil, pero es importante realizarlo para evitar los tratamientos agresivos, como la terapia prolongada con esteroides y especialmente la esplenectomía que son innecesarios en el síndrome de Sebastián.
Las macrotrombocitopenias pueden estar subestimadas, y se recomienda obtener una historia familiar detallada con especial énfasis en una historia de trombocitopenia, sordera, nefritis o fallo renal cuando evaluamos a un niño con trombocitopenia.[24] Es importante investigar la posibilidad de este tipo de enfermedad en los familiares y pacientes con trombocitopenia, interesándose especialmente por la historia familiar de manifestaciones clínicas renales, sordera o catarata.
Tratamiento
La transfusión profiláctica de plaquetas está indicada en pacientes con trombocitopenia a los que hay que practicar algún procedimiento invasivo. Dependiendo del territorio anatómico donde se vaya a realizar el procedimiento y de la naturaleza del mismo, variará el soporte transfusional. Como guía, en ausencia de otra coagulopatía asociada, se recomiendan recuentos plaquetarios superiores a 50 000 plaquetas/mm3. El tratamiento con este hemoderivado no está indicado en las trombocitopenias periféricas de causa autoinmune, excepto en caso de presentar una hemorragia grave en el SNC o en tracto digestivo.[22]
En pacientes anestesiados con alguno de los desórdenes que se incluyen en el síndrome MYH9 (el síndrome de Sebastian, anomalía de May-Hegglin, etc) se ha descrito la utilización, sin incidencias, de agentes anestésicos inhalatorios y relajantes musculares en el contexto de una anestesia general.[25][26] Así mismo se ha realizado anestesia espinal para cesárea, después de transfundir plaquetas, sin incidencias; en estos casos se recomienda un manejo anestésico programado, incluida una información exhaustiva a la paciente, y una cuidadosa coordinación obstétrica y anestésica.[27][28]
Referencias
- ↑ a b Pujol-Moix N. Macrotrombocitopenias constitucionales sin anomalías funcionales valorables. En: Pujol-Moix N, ed. Trombocitopenias. Madrid: Mosby/ Doyma, 1995; 313-322.
- ↑ a b Greinacher A, Nieuwenhuis HK, White JG. Sebastian platelet syndrome: a new variant of hereditary macrothrombocytopenia with leukocyte inclusions. Blut 1990; 61:282-288
- ↑ Martignetti J. Five (un) easy pieces: the MYH9-related giant platelet syndromes. Haematologica 2002; 87:897-8.
- ↑ May R. Leukozyteneinschlusse. Dtsch Arch Klin Med 1909; 96:1.
- ↑ Síndrome de Epstein
- ↑ Síndrome de Fechtner
- ↑ Peterson LC, Rao KV, Crosson JT, White JG. Fechtner syndrome-a variant of Alport´s syndrome with leukocyte inclusions and macrothrombocytopenia. Blood 1985; 65:397.
- ↑ Gershoni-Baruch R, Baruch Y, Viener A, Lichtig C. Fechtner syndrome: clinical and genetic aspects. Am J Med Gen 1988; 31:357-367.
- ↑ Alport AC. Hereditary familial congenital hemorrhagic nephritis. Br Med J 1927; 1:504
- ↑ Greinacher A, Nieuwenhuis HK, White JG. Sebastian platelet syndrome: a new variant of hereditary macrothrombocytopenia with leukocyte inclusions. Blut 1990; 61:282-288.
- ↑ Kelley MJ, Jawien W, Ortel TL, Korczak JF. Mutation of MYH9, encoding non-muscle myosin heavy chain A, in May-Hegglin anomaly. Nat Genet 2000; 26:106-8.
- ↑ Seri M, Cusano R, Gangarossa S, Caridi G, Bordo D, Lo Nigro C, et al. Mutations in MYH9 result in the May-Hegglin anomaly, and Fechtner and Sebastian syndromes. Nat Genet 2000; 26:103-5.
- ↑ a b Heath KE, Campos-Barros A, Toren A, Rozenfeld-Granot G, Carlsson LE, Savige J, et al. Nonmuscle myosin heavy chain IIA mutations define a spectrum of autosomal dominant macrothrombocytopenias: May-Hegglin anomaly and Fechtner, Sebastian, Epstein, and Alport-like syndromes. Am J Hum Genet 2001; 69:1033-45.
- ↑ Kunishima S, Matsushita T, Kojima T, Amemiya N, Choi YM, Hosaka N, et al. Identification of six novel MYH9 mutations and genotype-phenotype relationships in autosomal dominant macrothrombocytopenia with leukocyte inclusions. J Hum Genet 2001; 46:722-9.
- ↑ Kunishima S, Kojima T, Matsushita T, Tanaka T, Tsurusawa M, Furukawa Y, et al. Mutations in the NMMHC-A gene cause autosomal dominant macrothrombocytopenia with leukocyte inclusions (May-Hegglin anomaly/Sebastian syndrome). Blood 2001; 97: 1147-1149.
- ↑ Seri M, Savino M, Bordo D, Cusano R, Rocca B, Meloni J, et al. Epstein syndrome: another renal disorder with mutations in the nonmuscle myosin heavy chain 9 gene. Hum Genet 2002; 110:182-6.
- ↑ Toren A, Amariglio N, Rozenfeld-Granot G, Simon AJ, Brok-Simoni F, Pras E, et al. Genetic linkage of autosomal-dominant Alport syndrome with leukocyte inclusions and macrothrombocytopenia (Fechtner syndrome) to chromosome 22q11-13. Am J Hum Genet 1999; 65:1711-7
- ↑ Kunishima S, Kojima T, Tanaka T, Kamiya T, Ozawa K, Nakamura Y, et al. Mapping of a gene for May-Hegglin anomaly to chromosome 22q. Human Genet 1999; 105:379-83.
- ↑ Martignetti JA, Heath KE, Harris J, Bizarro N, Savoia A, Balduini CL, et al. The gene for May-Hegglin anomaly localizes to a <1Mb region on chromosome 22q12.3-13.1. Am J Hum Genet 2000; 66:1449-54
- ↑ Cusano R, Gangarossa S, Forabosco P, Caridi G, Ghiggeri GM, Russo G, et al. Localisation of the gene responsible for Fechtner syndrome in a region <600 Kb on 22q11-qq13. Eur J Hum Genet 2000; 8:895-9.
- ↑ Di pumpo M, Noris P, Pecci A, Savoia A, Seri M, Ceresa IF, et al. Defective expression of GPIb/IX/V complex in platelets from patients with May-Hegglin anomaly and Sebastian syndrome. Haematologica 2002; 87:943-7.
- ↑ a b Algora M, Fernández A, Gómez JL, Martín C, Prats I, Puig N, et al. Guía sobre la indicación de la transfusión de glóbulos rojos, plaquetas y productos plasmáticos en España. Med clin 1999; 113:471-4.
- ↑ Waters AH. Autoimmune thrombocytopenia: clinical aspects. Semin Hematol 1992; 29:18.
- ↑ Young G, Luban NL, White JG. Sebastian syndrome: case report and review of the literature. Am J Hematol 1999; 61: 62-65
- ↑ Síndrome de Sebastian
- ↑ Suzuki H, Fukuda H, Hirabayashi Y, Saitoh K, Igarashi T, Shimizu R. Anesthetic management of a patient with May-Hegglin anomaly [abstract]. Masui 2000; 49:899-900
- ↑ Nelson LH, Dewan DM, Mandell GL. Obstetric and anesthetic considerations in the May-Hegglin anomaly. A case report. J Reprod Med 1993; 38:311-3.
- ↑ Kotelko DM. Anaesthesia for caesarean delivery in a patient with May-Hegglin anomaly. Can J Anaesth 1989; 36:328-30.